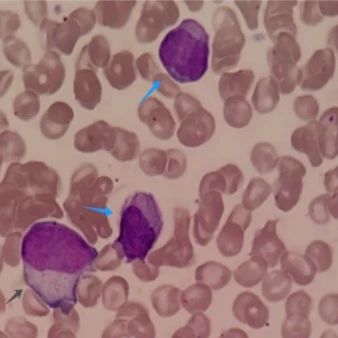

临床案例
-

罕见δ合并β地贫孕前筛查病例分析
2025-03-19 -

患者提问:女友患“接吻病”,还能亲亲吗?
2025-03-18 -

膝关节置换之殇:不可小觑的表皮葡萄球菌感染
2025-03-17 -

孕妈妈需警惕的“冷血杀手”
2025-03-17 -

成见如山!检验人的「申公豹式委屈」:这4大真相,患者必须知道
2025-03-16 -

骨折背后的隐情
2025-03-16 -

一例痰涂片之“鬼影现象”
2025-03-16 -

孕妇突然血小板下降究竟为哪般?
2025-03-15 -

急性混合细胞白血病-髓系与淋系携手作乱
2025-03-15 -

一蚊之微 血案成谜
2025-03-14 -

年轻人左耳反复流脓,原来是结核在作怪!
2025-03-13 -
在血常规复检中发现大问题
2025-03-13 -

一例CTC监测提前预示胰腺癌根治术后复发与指导治疗的案例分享
2025-03-12 -

甲胎蛋白异常升高之谜
2025-03-11 -

产后大出血,如何权衡输血利弊?
2025-03-11 -

一例隐匿性HBV感染分享
2025-03-10 -

健康的新手妈妈,甲胎蛋白却高达9000+,为啥?
2025-03-10 -

溶血背后隐匿的淋巴瘤谜团
2025-03-09 -

一例乳糜血引起的假性危急值及相关知识拓展
2025-03-09 -

穿“裙子”细胞,是善是恶?
2025-03-08




